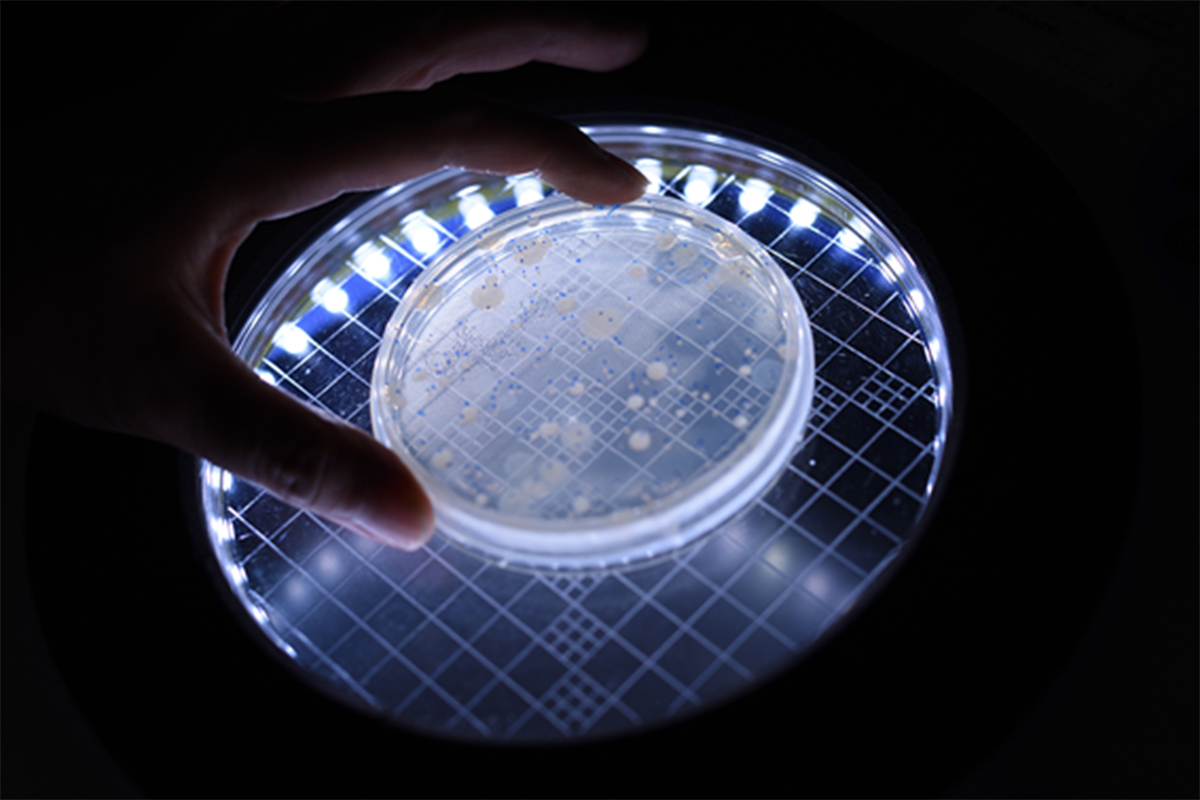

卓越的生產廠房
欧宝网页版登录入口近年來深耕研發,成果卓越,除了具備獨特技術平台、專業踏實的研發團隊,以及國際策略合作及行銷能力,並以關 懷病患的需求出發,以創新研發為目標,拓展專業技術能力, 積極開發符合國際標準之高品質產品。







實驗室介紹

設置多項高階精密儀器以及專用的分析設備,由合格的專業分析人員執行嚴謹的品質管制試驗,以確保產品品質符合最新國際規範。



實驗室設備
化學實驗室
HPLC
高溫灰化爐
紅外線光譜儀
氣相層析系統
定量噴霧劑自動系統
超純水製造機
Empower 數據管理系統
LIMS 實驗室資料系統







微生物實驗室

層流操作台
菌落計數器
雙門滅菌釜
恆溫培養箱
總有機碳分析儀
液態氮氣儲存桶
實驗室冷藏櫃
支援系統

藥廠支援系統分為空調、純水、空壓等三大系統,是支援生產與確保品質 相當重要的一環。



空調箱
主要用途為恆溫恆濕、控制環境的清淨度、避免污染及避免交叉污染,以確保產品品質。


空壓機
採無油式空壓機設計,並符合 ISO 8573 之品質規範,避免影響產品品質。

純水系統
採符合藥典 USP34 版純水規格設計,主要提供生產區用水 。
BIBO ( 袋進袋出過濾設備 )
總共有 23 台 BIBO,為保護環境、避免污染 產品及保護人員安全所設置 。


冰水機
提供空調箱的冰水來源 。
